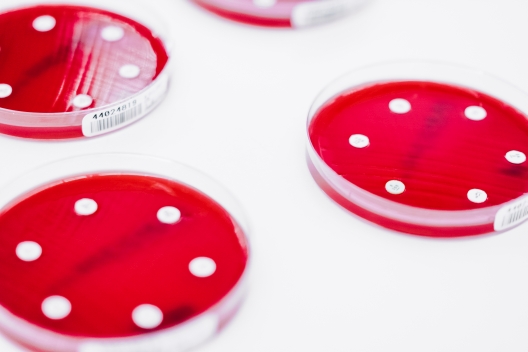

Gelsenkirchen/Iserlohn/Siegen – 28. Juni 2018
Um Antibiotika-Resistenzen einzudämmen bzw. eine gezielte Verordnung von Antibiotika abzusichern, wird der EBM zum 01.07.2018 angepasst. Mit dem Beschluss werden mehrere labordiagnostische Untersuchungen zur schnellen und qualitätsgesicherten Antibiotikatherapie an den Stand von Wissenschaft und Technik angepasst.
Damit sich die Kosten für mikrobiologische Tests nicht auf den Wirtschaftlichkeitsbonus auswirken, wurde die Kennziffer 32004 in den EBM aufgenommen.
Folgende Leistungen stehen ab dem 01.07.2018 zur Verfügung:
GOP 32459: Procalcitonin (PCT) bei Infektionen der Atemwege
GOP 32692: Differenzierung gezüchteter Pilze mittels MALDI-TOF – Massenspektrometrie
GOP 32759: Differenzierung von in Reinkultur gezüchteten Bakterien mittels MALDI-TOF-Massenspektrometrie
GOP 32772: Semiquantitative nach EUCAST oder CLSI ausgewählte Empfindlichkeitsprüfungen von in Reinkultur gezüchteten klinisch relevanten gramnegativen Bakterien aus einem Material gegen mindestens fünf Standardtherapeutika sowie mindestens drei für den Nachweis von Resistenzmechanismen relevanten Leitsubstanzgruppen
GOP 32773: Semiquantitative nach EUCAST oder CLSI ausgewählte Empfindlichkeitsprüfungen von in Reinkultur gezüchteten klinisch relevanten grampositiven Bakterien aus einem Material gegen mindestens fünf Standardtherapeutika sowie mindestens drei für den Nachweis von Resistenzmechanismen relevanten Leitsubstanzgruppen
GOP 32774: Zuschlag zu der GOP 32772 bei gramnegativen Bakterien für die Durchführung von phänotypischen Bestätigungstesten bei Multiresistenz gegen die für die Bakterienart relevante Leitsubstanz
GOP 32775: Zuschlag zu der GOP 32773 bei grampositiven Bakterien für die Durchführung von phänotypischen Bestätigungstesten bei Multiresistenz gegen die für die Bakterienart relevante Leitsubstanz
Im Gegenzug werden die Empfindlichkeitsprüfungen nach den GOP 32766 und 32767 gestrichen und in den GOP 32772 und 32773 neu gefasst.
Sollten Sie Fragen zum Setzen der Ausnahmekennziffer haben, hilft Ihnen unser Außendienst gerne unter 01 73/54 44 478 (Andrea Hövelmann) bzw. 01 73/53 01 755 (Silvia Gruda) weiter.